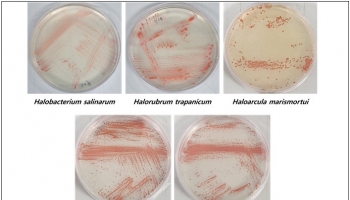

바이오
- [플라스틱 지구]미세플라스틱이 뇌혈관 막는다…기억력·운동신경 감퇴
- 2025-01-28 [조인준]
- HLB, 미세 채혈도구 '랜싯' FDA 판매 승인
- 2025-01-21 [김나윤]
- HLB 간암신약, 美FDA 마지막 관문 'CMC 실사' 완료
- 2025-01-14 [김나윤]
- 베리스모, 혈액암 CAR-T 치료제 임상1상 첫 투여
- 2025-01-13 [손민기]
- "항생제 내성균으로 25년간 4000만명 사망한다"
- 2025-01-06 [김나윤]
- '블루라이트'...알고보니 더 교묘하게 눈건강 위협
- 2025-01-06 [조인준]
- HLB생명과학 일회용주사기, 美 FDA 시판허가
- 2025-01-02 [김나윤]
- 셀트리온, 자가면역질환 치료제 '스테키마' 美 판매허가
- 2024-12-18 [김나윤]
- CDMO법인 '셀트리온바이오솔루션스' 출범..."2031년 매출 2조 목표"
- 2024-12-17 [김나윤]
- HLB·KAIST 전격 협력...신약 연구·교육 손잡는다
- 2024-12-16 [김나윤]
- HLB제약, 장기지속형주사제 개발 속도..'제형 특허' 확보
- 2024-12-13 [김나윤]
- 염전 미생물에서 피부보호와 신경세포 흥분억제 유전자 발견
- 2024-12-11 [김나윤]